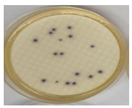
Chemengineering 09 00077 i001
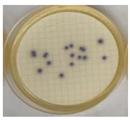
Chemengineering 09 00077 i003
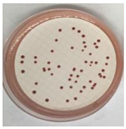
Chemengineering 09 00077 i005
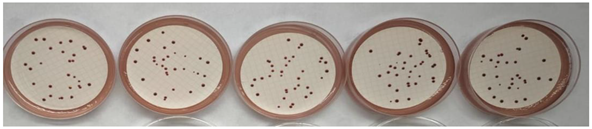
Chemengineering 09 00077 i006

Abstract
Among the various available synthesis approaches, hydrolytic precipitation offers a simple, cost-effective, and scalable route for producing phase-pure NiO with a controlled morphology and crystallite size. However, the influence of calcination temperature on its crystalline phase, particle size, and antimicrobial activity remains an active field of research. This study aims to investigate the structural, morphological, and antibacterial properties of NiO nanoparticles synthesized via hydrolytic methods and thermally treated at different temperatures. XRD data indicate the presence of the hexagonal crystallographic phase of NiO (space group 166: R-3m), a structural variant less commonly reported in the literature, stabilized under mild hydrolytic synthesis conditions. The average crystallite size increases significantly from 4.97 nm at 300 °C to values of ~17.8 nm at 500–700 °C, confirming the development of the crystal lattice. The ATR-FTIR analysis confirms the presence of the characteristic Ni–O band for all samples, positioned between 367 and 383 cm−1, with a reference value of 355 cm−1 for commercial NiO. The displacements and variations in intensity reflect a thermal evolution of the crystalline structure, but also an important influence of the size of the crystallites and the agglomeration state. The results reveal a systematic evolution in particle morphology from porous, flake-like nanostructures at 300 °C to dense, well-faceted polyhedral crystals at 900 °C. With an increasing temperature, particle size increases. EDS spectra confirm the high purity of the NiO phase across all samples. Additionally, the NiO nanoparticles exhibit calcination-temperature-dependent antibacterial activity, with the complete inhibition of Escherichia coli and Enterococcus faecalis observed after 24 h for the sample calcined at 300 °C and over 90% CFU reduction within 4 h. A significant reduction in E. faecalis viability across all samples indicates time- and strain-specific bactericidal effects. Due to its remarkable multifunctionality, NiO has emerged as a strategic nanomaterial in fields ranging from energy storage and catalysis to antimicrobial technologies, where precise control over its structural phase and particle size is essential for optimizing performance.
1. Introduction
Nickel oxide (NiO) is a p-type transition metal oxide with a face-centered cubic (NaCl-type) crystal structure and a wide band gap ranging from 3 to 4 eV, characteristics that make it highly attractive for diverse applications, including photocatalysis, gas sensing, energy storage, and antimicrobial technologies. Its notable chemical stability, optoelectronic behavior, and biological activity have positioned NiO as a key material in the current research landscape on multifunctional nanomaterials [1].
The physicochemical properties of NiO are strongly dependent on the synthesis route used and its associated process parameters. Numerous techniques have been employed to produce NiO nanoparticles with tailored morphologies and dimensions, such as chemical precipitation, sol–gel processing, hydrothermal synthesis, and green synthesis methodologies [2,3,4,5,6,7,8,9,10]. For instance, the pH of the synthesis medium (acidic vs. basic) significantly influences particle size, dispersion, and magnetic behavior, while post-synthesis thermal treatment modulates crystallinity and optical properties [6,7].
NiO has also attracted considerable attention as an antibacterial agent, with its antimicrobial activity attributed to mechanisms including the generation of reactive oxygen species (ROS), the release of Ni2+ ions, and interactions with bacterial membranes [11,12,13]. Despite the extensive literature on NiO synthesis and applications, there remains a paucity of systematic studies elucidating the correlation between calcination temperature and the resultant structural, morphological, optical, and antibacterial characteristics of hydrolytically synthesized NiO nanoparticles.
Table 1 summarizes the elaboration by chemical methods and characteristics of obtained NiO nanoparticles.
Table 1.
Chemical methods and characteristics of NiO nanoparticles.
Green synthesis represents an environmentally benign alternative to conventional chemical methods, employing biological resources such as plant extracts (leaves, roots, fruits, and flowers) and microorganisms (bacteria, algae, and fungi) as reducing and stabilizing agents [11]. This sustainable approach has garnered increasing interest due to its simplicity, cost-effectiveness, and ecological compatibility. A synthetic understanding is presented in Table 2.
Table 2.
Biological methods and characteristics of NiO nanoparticles.
The antibacterial and therapeutic potential of NiO nanoparticles synthesized via green methods underscores the importance of optimizing biogenic synthesis parameters to tailor nanoparticle properties.
The paper aims to provide a significant contribution to the field of nickel oxide nanomaterials by demonstrating, for the first time, the reproducible formation of a hexagonal crystalline phase of NiO (space group 166: R-3m) via a simple room-temperature hydrolytic precipitation route, without the use of surfactants, templating agents, or high-pressure equipment. While the face-centered cubic (FCC) structure is commonly reported under similar thermal conditions, the controlled pH environment and nanometric crystallite dimensions (~4.97 nm at 300 °C) promote the stabilization of this metastable hexagonal structure, rarely encountered in the literature.
A second key contribution lies in the temperature-dependent antibacterial assessment, which reveals the complete inhibition of E. coli after 24 h, outperforming several green and hydrothermal synthesis approaches cited in the literature. Furthermore, the study correlates calcination temperature with progressive morphological transitions (from flake-like to polyhedral particles), enabling surface properties tailored for specific applications.
The present research not only proposes a low-cost, environmentally benign, and scalable synthesis strategy, but also highlights the functional implications of controlling structural phase and nanomorphology for optimizing antimicrobial performance. The method holds promise for the practical integration of NiO into biomedical, water purification, and catalytic applications. Future research should focus on elucidating the mechanisms of antibacterial action, improving reproducibility, and ensuring the safety and compatibility of NiO nanomaterials for clinical and environmental applications.
2. Materials and Methods
The hydrolytic synthesis of nickel oxide (NiO) was performed using nickel nitrate hexahydrate (Ni(NO3)2·6H2O) as a precursor, dissolved in 50 mL of deionized water to obtain a 1 M solution. A 1 M potassium hydroxide (KOH) solution, also in a volume of 50 mL, was prepared separately and added dropwise at room temperature under continuous stirring. The initial pH of the nickel nitrate solution was measured to be 5.39.
To monitor the hydrolysis process and identify the critical region of precipitation, the evolution of pH was recorded as a function of the volume of KOH solution added. The data was used to construct a titration curve representing pH versus volume of KOH (mL), accompanied by the corresponding first derivative (dpH/dV), as shown in Figure 1.
Figure 1.
Graphical representation of pH variation.
This analytical approach allows for the determination of the optimal hydrolysis range, as the inflection point on the dpH/dV curve corresponds to the onset of rapid pH change, indicating the formation of nickel hydroxide (Ni(OH)2) precipitate. The subsequent thermal decomposition of this intermediate resulted in the formation of NiO nanoparticles.
The identified hydrolysis domains are as follows:
KOH at 0–10 mL: At this stage, the pH initially decreases slightly and then starts to gradually increase, while dpH/dV decreases. This behavior indicates an acid neutralization phase, without the significant hydrolysis of nickel ions.
KOH at 10–25 mL: Up to this point, the pH increases and dpH/dV reaches a first minimum, signaling the beginning of hydrolysis reactions and the formation of colloidal or gelatinous species of the Ni(OH)2 type. This is the initial stage of the hydrolysis process.
KOH at 25–40 mL: In this range, the pH stabilizes around 6.4–6.6 and the dpH/dV shows several oscillations, indicating the strong hydrolysis, coagulation, and growth of Ni(OH)2 particles. This is the main phase in which the precursors for NiO (which will result from calcination) are formed.
KOH at 40–50 mL: In this last stage, the pH starts to increase again and the dpH/dV drops significantly, signaling that the system has reached saturation. Hydrolysis is practically complete, and the solution tends towards a basic environment.
Thus, the active hydrolysis range can be delimited between 10 and 40 mL of KOH, where the essential processes of the formation and transformation of Ni(OH)2 species necessary for the final production of NiO take place.
After the mixture had been completely added from the burette, the resulting solution was dispersed in an ultrasonic bath for 10 min. Applying ultrasound to the Ni(OH)2 suspension improved dispersion, broke aggregates, and could accelerate nucleation and uniform particle growth. This step optimized the quality of the NiO-generating precursor. It was then filtered to collect the wet solid, removing excess dissolved salts, and dried in an oven at 60 °C for 2 h to obtain a solid material.
After drying, the resulting solid Ni(OH)2 was finely ground in a mortar to obtain 2.587 g of uniform powder. This step improved homogeneity and reactivity in the final step. From this powder, 0.5 g was calcined at different temperatures (300 °C, 500 °C, 700 °C, and 900 °C) to determine the optimal temperature for obtaining nanostructures, according to the following reaction:
Ni(OH)2 → NiO + H2O↑
The process is schematically represented in Figure 2.
Figure 2.
Work stages of NiO nanoparticles elaboration: (a) hydrolysis; (b) US treatment; (c) filtration; (d) grinding; (e) calcination.
The structural characterization of the NiO powders calcined at 300 °C, 500 °C, 700 °C, and 900 °C was conducted using a Rigaku Ultima IV X-ray diffractometer (Rigaku Corporation, Tokyo, Japan). The instrument was equipped with a D/teX Ultra high-speed detector, a graphite monochromator to filter Kβ radiation, and a vertical goniometer configured in Bragg–Brentano geometry for optimal focusing.
X-ray diffraction patterns were acquired using CuKα radiation (λ = 1.5406 Å) over a 2θ range from 22.00° to 85.00°, with a step size of 0.020° and a scanning speed of 1.5°/min. The applied tube voltage and current were maintained at 45 kV and 45 mA, respectively, ensuring the high-resolution detection of the crystalline phases. This analysis allowed for the identification of the crystallographic structure, estimation of the crystallite size, and observation of the phase evolution with an increasing calcination temperature.
Attenuated Total Reflectance Fourier Transform Infrared (ATR-FTIR) spectroscopy was employed to investigate the vibrational characteristics of the NiO powders calcined at 300 °C, 500 °C, 700 °C, and 900 °C. The spectra were recorded using a Bruker Tensor 27 spectrometer (Bruker Optics GmbH, Ettlingen, Germany), in the spectral range of 4000–350 cm−1. The obtained spectra were systematically compared with those of commercially available NiO, serving as a reference.
The morphological characteristics of the nanostructured nickel oxide (NiO) powders were examined using a Hitachi SU82300 ultra-high-resolution field-emission microscope (Hitachi High-Tech Corporation, Hitachinaka, Japan). Prior to imaging, the samples were dispersed onto conductive carbon tape to ensure optimal electron conductivity and minimize charging effects. SEM imaging was conducted at an accelerating voltage of 25 kV under ultra-high vacuum. These conditions enabled high-resolution observation of particle shape, size, and surface texture. Elemental composition was determined via EDS analysis on an SU 5000 scanning electron microscope (Hitachi High-Tech Corporation, Hitachinaka, Japan) equipped with an energy-dispersive X-ray spectroscopy (EDS) system for elemental analysis. EDS was performed directly on selected regions of interest.
The antibacterial properties of the nickel oxide (NiO) nanoparticles synthesized hydrolytically from Ni(NO3)2·6H2O and subsequently calcined at 300 °C, 500 °C, 700 °C, and 900 °C were assessed against the standard bacterial strains Escherichia coli ATCC 25922 and Enterococcus faecalis ATCC 29212. The experimental protocol was based on membrane filtration followed by colony counting on selective culture media.
Serial decimal dilutions of bacterial suspensions were performed to obtain countable colonies on membrane filters. For enumeration, Merck culture media were employed: Chromocult® Coliform Agar for E. coli and Slanetz and Bartley Agar for E. faecalis. Cultivation was conducted under conditions specific to each microorganism, in accordance with standardized microbiological procedures. Prior to testing, all samples were subjected to surface decontamination via exposure to ultraviolet (UV) light for 15 min to eliminate any environmental microbial contamination. Prior to assessing the antibacterial activity of the NiO samples, the artificially contaminated suspension was evaluated to ensure that the microbial load fell within a quantifiable range. Positive control measurements confirmed increases of approximately 20 CFU/mL for E. coli and 50 CFU/mL for E. faecalis, establishing a baseline for comparative analysis.
To test the elaborated NiO powders, testing was performed with an artificially contaminated sample containing a culture of E. coli and E. faecalis to observe their bactericidal effects at intervals of 4 h and 24 h from direct contact compared to commercial NiO.
A contaminated sample consisted of 2 mg of NiO powder, 1 mL of bacterial suspension (E. coli and E. faecalis), and 9 mL of sterile distilled water, homogenized in a tube with a Vortex. In total, 1 mL of sample was filtered from this mixture, which meant a concentration of 0.2 mg/mL. The resulting colony counts were used to evaluate the bactericidal effect of the NiO nanoparticles as a function of calcination temperature and exposure time.
3. Results
3.1. ATR-FTIR Analysis
To investigate the formation of the oxide phase and the purity of the synthesized compounds, the ATR-FTIR spectra of the NiO powders obtained by calcination at temperatures of 300 °C, 500 °C, 700 °C, and 900 °C were recorded, compared to a commercial NiO sample, as presented in Figure 3. This comparative analysis enabled the identification of characteristic Ni–O vibrational modes and provided insight into the structural changes induced by thermal treatment. The evolution of specific absorption bands with an increasing calcination temperature was used to assess the degree of crystallinity and the removal of residual hydroxyl or organic functional groups from the precursor materials.
Figure 3.
ATR-FTIR spectra corresponding to the powders NiO/300 (blue), NiO/500 (red), NiO/700 (purple), and NiO/900 (green) compared with the commercial NiO spectrum (black).
The band characteristic of the Ni–O stretching vibration was observed at 355 cm−1 in the case of commercial NiO, which reflects a well-developed crystalline structure. For the powders obtained by synthesis, the position of this band varied depending on the calcination temperature, as follows: 370 cm−1 at 300 °C, 367 cm−1 at 500 °C, 370 cm−1 at 700 °C, and 383 cm−1 at 900 °C. In the spectra of the powders calcined at 300 °C and 500 °C, the presence of broad bands around 3400 cm−1 and 1600 cm−1 was noted, attributed to O–H vibrations and H–O–H deformations from adsorbed water molecules or residual hydroxides. These thin shifts indicate changes in the oxide lattice structure, associated with the evolution of crystallinity and the relaxation of lattice stress. Also, a weak band around 1380 cm−1 suggested the persistence of residual anions (NO3−) from the metal precursors. Also, significant variations in the intensity of the Ni–O band were noted, which initially increased with temperature but decreased sharply at 900 °C, where the absorption reached a maximum of only 0.2.
3.2. XRD
The XRD spectra of the final powders after calcination show a single phase of pure NiO, DB card no. 04-013-0889 according to PDF5+2024-DB.
The XRD diffraction spectra obtained for the final NiO powders after calcination at different temperatures (300 °C, 500 °C, 700 °C, and 900 °C) are shown in Figure 4. All samples show peaks characteristic of a single crystalline phase of nickel oxide (NiO), according to the standard PDF-5+ 2024: 04-013-0889. The absence of any additional peaks confirms the purity of the phase obtained, without secondary phases. For the sample calcined at 300 °C, it is observed that the peaks have lower intensities and larger widths, which indicates a reduced degree of crystallinity and small crystallite sizes. With increasing the calcination temperature to 500 °C, the peaks become more intense and better defined, signaling an increase in structural order and crystallite size.
Figure 4.
Superposition of NiO spectra prepared by hydrolytic synthesis.
At 700 °C, the XRD spectrum shows a further intensification of the peaks and their narrowing, which suggests a clear evolution of crystallinity and a more pronounced development of the NiO structure. The sample calcined at 900 °C presents the most intense and well-defined reflections, which indicates a very well-defined crystalline structure.
The structure identified in all cases is of the hexagonal type, belonging to the space group 166:R-3m. The values of the lattice parameters fall within very close ranges, which shows a good structural stability regardless of the calcination temperature. The crystallographic parameters are presented in Table 3.
Table 3.
Crystallographic parameters of calcined samples.
The average crystallite size varies with temperature. At 300 °C, a small value of approximately 4.97 nm is observed, indicating a crystallized structure. With increasing the temperature to 500 °C and 700 °C, the crystallite sizes increase, indicating an improvement in the degree of atomic organization in the NiO structure. At 900 °C, an unexpected decrease in crystallite size to 8.27 nm is observed, possibly due to the appearance of internal defects, structural stress, or inefficient local recrystallization following excessive sintering. This apparent decrease can be attributed to possible granular segregation or local fragmentation caused by internal stresses accumulated at high temperatures. The unit cell volume remains relatively constant (~55 Å3), indicating the structural stability of the NiO phase. Correlating these results with the FTIR data, it is found that the powders calcined at 700 °C offer an optimal balance between purity, crystallinity, and crystallite size, reflected in a clean spectrum, the correct positioning of the Ni–O band, and a well-developed crystalline structure.
The ATR-FTIR spectra complement the information obtained by XRD, confirming the formation of the oxide lattice by identifying the vibration modes characteristic of Ni–O bonds. The band specific to the Ni–O tensile vibration is identified at 370 cm−1 (300–700 °C) and moves to 383 cm−1 for the sample calcined at 900 °C, indicating a local reorganization of the network and a relaxation of crystalline grid tensions. The intensity of this band increases steadily up to 700 °C, a sign of increased crystallinity, but decreases sharply at 900 °C, a behavior correlated with the decrease in crystallite size observed in the XRD analysis. The almost constant value of the crystal parameters determined by XRD, together with the absence of major structural changes in the infrared absorption zone corresponding to the Ni-O vibrations, confirm the structural stability of the NiO phase throughout the investigated thermal range.
Compared to the research in [2,3,4,5,6], the present study, despite using a simplified method (hydrolysis at room temperature), resulted in average crystallite sizes between 4.97 and 17.85 nm. As opposed to the more commonly reported face-centered cubic (FCC) structure of NiO (space group Fm-3m), typically observed in the literature for similar calcination temperatures [2,3,4,5,6], we reported a hexagonal crystal structure (space group 166:R-3m).
The formation of this hexagonal phase can be attributed to several interdependent factors, as follows:
- Precursor chemistry and synthesis conditions: The use of a 1 M Ni(NO3)2·6H2O solution and room-temperature hydrolysis in alkaline medium promotes a kinetically controlled nucleation process. This may favor the stabilization of a metastable hexagonal arrangement during the early stages of crystallization.
- Low-temperature precipitation and mild hydrolysis: The cold precipitation process used here can promote the directional growth of nanocrystallites, leading to anisotropic structural stabilization. Such conditions have been reported to occasionally favor less common phases in transition metal oxides, especially when particle sizes are in the sub 10 nm range.
- Nanometric crystallite size: The calculated average crystallite size of 4.97 nm for the sample calcined at 300 °C falls within a domain where size-induced structural distortion and surface energy minimization effects become dominant. In this range, thermodynamically metastable phases can be stabilized due to their lower surface energy.
- Absence of sintering and rapid thermal evolution: The transition to the cubic phase is often favored under prolonged thermal exposure or aggressive sintering conditions. The mild calcination protocol used here (moderate temperatures and relatively short durations) appears to preserve the hexagonal structure, particularly evident in the sample calcined at 700 °C, which exhibits a well-defined and narrow peak profile without phase transition.
This suggests more efficient size control at low temperatures, which is favorable for surface-sensitive nanotechnology applications.
3.3. SEM-EDS Analysis
The morphology of nickel oxide (NiO) particles synthesized via a room-temperature co-precipitation method and subsequently calcined at 300 °C was examined using scanning electron microscopy (SEM) at a magnification of 500,000×. The SEM micrograph shown in Figure 5a highlights a non-uniform morphology, with particles of irregular shapes and variable sizes, characteristic of nanostructured materials. A tendency of the particles to form aggregates and flake-like structures is observed, suggesting a specific synthesis process with the possible directed growth of crystallites. These features are particularly advantageous for applications in energy storage devices such as supercapacitors, as well as in catalysis and chemical sensing, where enhanced surface activity and diffusion pathways are critical for improved performance.
Figure 5.
(a) SEM micrograph and (b) EDS spectrum elemental composition of NiO/300 particles.
The corresponding EDS spectrum (Figure 5b) indicates the predominant presence of nickel (79.83 wt%) and oxygen (20.17 wt%), which is consistent with the stoichiometry of nickel oxide (NiO). The absence of other elements in the spectrum confirms the high purity of the sample, suggesting the efficiency of the synthesis method used. The mass ratio obtained is close to the theoretical values corresponding to the NiO compound, supporting the hypothesis of the formation of this oxide in a predominantly stoichiometric manner, as presented in Table 4.
Table 4.
Elemental composition of NiO/300 powder.
To evaluate the influence of calcination temperature on the morphological and compositional characteristics of nanostructured nickel oxide (NiO), a sample heat-treated at 500 °C was analyzed. The SEM micrograph, at a magnification of 300,000× (Figure 6a), reveals larger particles and a more uniform and densely packed granular morphology, with well-defined and discrete nanoparticle boundaries. The particles exhibit a predominantly spherical to slightly polyhedral shape, indicating enhanced crystallization and grain growth due to the higher thermal energy at 500 °C. This transformation can be attributed to the sintering and coalescence of primary nanoparticles during calcination, which promotes thermodynamically favored particle shapes. This morphology is advantageous for applications that require a higher structural stability and better electrical conductivity, such as in solid-state devices, gas sensors, and electrode materials in lithium-ion batteries.
Figure 6.
(a) SEM micrograph; (b) particle size distribution; and (c) EDS spectrum of NiO/500 particles.
The particle size distribution histogram for NiO calcined at 500 °C (Figure 6b) supports the morphological features observed in the corresponding SEM micrograph (Figure 6a). The histogram exhibits a near-Gaussian distribution centered around 30 nm, with most particles ranging between 20 and 40 nm in diameter. The presence of a single, dominant peak indicates a narrow size distribution and a high degree of uniformity in particle growth.
The EDS spectrum (Figure 6b) shows a chemical composition dominated by nickel (85.03 wt%) and oxygen (14.97 wt%), as presented in Table 5. Compared to the sample calcined at 300 °C (79.83% Ni, 20.17% O), an increase in the proportion of nickel and a decrease in the detected oxygen are observed. This change can be attributed to the possible partial reduction of NiO or desorption of surface oxygen at higher temperatures. Such a combination of morphological uniformity and a moderate particle size is highly beneficial for applications requiring dimensional control and stable conductive pathways, including gas-sensing platforms, lithium-ion battery electrodes, and solid-state electronic devices.
Table 5.
Elemental composition of NiO/500 powder.
The SEM image of sample NiO/700 (Figure 7a) taken at 500,000× magnification indicates that the formation of NiO particles exhibits significant growth, resulting in irregularly shaped, coarsened structures with a broad particle size distribution. The data reveal a moderately broad, unimodal distribution centered around 28–30 nm, with most particles falling within the 20–40 nm range. The shape of the curve, although Gaussian-like, suggests the onset of particle coarsening, as a noticeable spread toward larger particle sizes is present, consistent with the early stages of particle fusion, as shown in Figure 7b.
Figure 7.
(a) SEM micrograph; (b) particle size distribution; and (c) EDS spectrum of NiO/700 particles.
This distribution (Figure 7b) aligns closely with the SEM observations (Figure 7a), which indicate irregularly shaped and coarsened particles because of significant grain growth.
Compared to the samples calcined at 300 °C and 500 °C, the 700 °C treatment leads to improved particle crystallinity and structural integrity.
This morphology of grain connectivity is beneficial for applications requiring a high electrical conductivity, thermal stability, and mechanical robustness, such as electrodes for solid-state devices or gas-sensing platforms operating at elevated temperatures.
The EDS spectrum (Figure 7c) reveals a chemical composition of 84.72% nickel and 15.28% oxygen by weight, indicated in Table 6. This proportion is close to that obtained for the sample calcined at 500 °C (85.03% Ni, 14.97% O), indicating the stabilization of the composition at high temperatures. The clear presence of the characteristic peak for nickel and the signal corresponding to oxygen confirms the persistence of the NiO compound, without detectable contamination.
Table 6.
Elemental composition of NiO/700 powder.
Figure 8a shows the SEM image of the sample calcined at 900 °C, acquired at 50,000× magnification. The particles exhibit polyhedral and cuboidal geometries, with smooth, clearly defined facets indicative of significant crystalline ordering. A pronounced transformation in particle morphology is evident at this temperature, characterized by the formation of well-faceted, large, and highly crystalline particles. This morphology reflects a fully developed crystalline structure, where particle fusion processes have been strongly activated by high thermal energy. The near elimination of intergranular voids and the crystallographically flat surfaces point to a material with a low surface area and minimal structural defects, which may be beneficial for applications requiring a high chemical stability, thermal endurance, or long-term mechanical integrity. The histogram shown in Figure 8b displays the particle size distribution for NiO particles subjected to calcination at 900 °C. The distribution is centered around 25–30 μm, with a range extending from approximately 15 to 50 μm. The Gaussian fit indicates a relatively broad and right-skewed distribution, signifying extensive particle growth and aggregation at this elevated temperature.
Figure 8.
(a) SEM micrograph; (b) particle size distribution; and (c) EDS spectrum of NiO/900 particles.
However, such dense, coarse-grained structures typically exhibit limited electrochemical activity due to the reduced active surface area and longer diffusion paths, making them less favorable for catalysis or energy storage applications compared to samples calcined at lower temperatures.
The EDS spectrum (Figure 8c) indicates a composition of 82.08% nickel and 17.92% oxygen by weight, as shown in Table 7. Compared to the sample calcined at 700 °C (84.72% Ni, 15.28% O), a slight increase in oxygen content is observed. This can be explained either by partial reoxidation of the surface during cooling or by the appearance of structural defects that facilitate oxygen adsorption.
Table 7.
Elemental composition of NiO/900 powder.
Calcination temperature plays a key role in defining the physicochemical properties of nanostructured nickel oxide. At 300 °C, the material exhibits a granular morphology with fine, agglomerated particles. As the temperature increases to 500 °C, densification of the structure and a clearer outline of the particles are observed, a sign that the synthesis is progressing towards a more ordered form. At 700 °C, agglomerations of cubic particles are formed. At 900 °C, obvious sintering is observed, with large particles and smooth surfaces, a sign of coalescence and crystallite growth. Advanced sintering may compromise the desired nanoscale structure, making it more suitable for applications where thermal stability is a priority.
A correlation between calcination temperature, morphology, and surface characteristics is shown in Table 8.
Table 8.
Correlation between calcination temperature–morphology–surface characteristics.
The morphological evolution of NiO particles as a function of calcination temperature reveals a clear transition from highly porous, nanostructured aggregates at 300 °C to large, well-crystallized polyhedral grains at 900 °C. Increasing the temperature enhances crystallinity and grain growth. These changes directly impact potential applications: low-temperature NiO is better suited for catalysis and energy, whereas high-temperature NiO offers a superior structural stability and conductivity, favorable for sensors and solid-state devices. Thus, tailoring the calcination temperature allows for the controlled tuning of NiO morphology for specific functional applications.
4. Antibacterial Properties
Given the limitations in performing in-house MIC and biocompatibility experiments, a comparative literature analysis was conducted to evaluate whether the NiO concentration used in this study (0.2 mg/mL) falls within the range of previously reported antibacterial and biocompatible applications. A summary of relevant studies is presented in Table 9, indicating the concentration ranges, particle sizes, target bacterial strains, and reported biocompatibility outcomes. In most studies, concentrations between 0.05 and 1 mg/mL demonstrated significant bactericidal effects against E. coli, S. aureus, B. subtilis, P. aeruginosa, and K. pneumonia, while maintaining acceptable cytocompatibility levels on mammalian cells (fibroblasts, osteoblasts, or keratinocytes). Additionally, green-synthesized and hydrothermally obtained NiO nanoparticles often exceeded 0.5 mg/mL in MIC assays without inducing acute cytotoxic effects.
Table 9.
Comparative literature analysis of NiO used in antibacterial tests.
This comparative overview confirms that the NiO nanoparticles synthesized in this work, characterized by a nanometric size (~4.97–17.85 nm) and tested at 0.2 mg/mL, align well with the effective and safe concentration intervals reported in the literature.
Therefore, the selected concentration of 0.2 mg/mL can be considered as being within a viable operational window for biomedical purposes, as long as it is supported by complementary toxicity evaluation in future work.
Following membrane filtration, the collected filtrates were cultured on selective media—Chromocult® Coliform Agar (CCA) for E.coli and Slanetz and Bartley Agar (SB) for E. faecalis—and incubated at 37 °C for 24 h. Colony-forming units (CFUs) were subsequently enumerated to quantify bacterial viability.
A negative control (Control−), composed only of sterile distilled water, confirmed the sterility and reliability of the procedure. A positive control (Control+), containing a known quantity of viable bacterial cells, demonstrated consistent bacterial survival during the experimental timeline. The experimental results are summarized in Table 10, Table 11 and Table 12.
Table 10.
Results of antibacterial tests of NiO com versus elaborated NiO on E. coli.
Table 11.
Results of antibacterial tests of NiO com versus elaborated NiO on E. faecalis.
Table 12.
Quantitative results of antibacterial tests of NiO com versus elaborated NiO on E. faecalis.
All tested samples demonstrated a remarkable efficiency in completely inhibiting E. coli after 24 h of contact, indicating an increased susceptibility of Gram-negative bacteria to the bactericidal effect of NiO. The results for E. coli at 4 h of contact ranged between 1 CFU/mL (NiO/300) and 12 CFU/mL (NiO/700 and NiO/900), highlighting a substantial reduction even at short exposure intervals. Of all the tested variants, NiO/300 showed the most pronounced early bactericidal activity on E. coli, with a reduction of over 90% in the bacterial load in the first 4 h, followed by complete eradication at 24 h.
The CFU evolution is represented in Figure 9. In the case of E. faecalis, a Gram-positive bacterium known for its robust cell wall structure and increased resistance to stress conditions, the antibacterial efficiency was influenced by both the type of NiO sample and the contact time. At 4 h, the number of CFU/mL remained relatively high (between 31 and 32 for the synthesized NiO samples), compared to the value of the commercial NiO (29 CFU/mL), suggesting moderate bacteriostatic activity. However, after 24 h, the NiO com. and NiO/300 samples achieved the complete inactivation of E. faecalis, while NiO/500–900 determined significant but incomplete reductions (between 8 and 10 CFU/mL). This behavior is explained by the structure of the E. coli cell wall, which is composed of a thin peptidoglycan layer (2–7 nm) and an outer membrane rich in lipopolysaccharides (LPSs). This configuration allows for the easy penetration of Ni2+ ions and reactive oxygen species (ROS), generated at the surface of NiO particles, leading to membrane destabilization and cell lysis. In addition, E. faecalis is known for its increased tolerance to stress, including alkaline pH, dehydration, and antimicrobial agents, as well as its ability to form protective biofilms.
Figure 9.
Graphical representation of CFU evolution.
These results highlight that the antimicrobial efficiency of NiO powders is influenced by several factors, as follows:
- Exposure time, especially essential for Gram-positive strains.
- Morphological structure, because samples obtained at low temperatures (NiO/300) seem to benefit from a more reactive morphology and flake-like elongated particles.
- Phase composition—higher temperatures (>700 °C) can lead to partial sintering and a reduction in the active area, which explains the decrease in efficiency for NiO/700 and NiO/900.
NiO/300 stands out as the best-performing sample, with rapid and efficient action on both types of bacteria, surpassing even commercial nickel oxide. This increased efficiency is correlated with the nanometric size of the crystallites (4.97 ± 0.4 nm), which favors surface reactivity, contributing to increased interaction with bacteria and the efficiency of the bactericidal mechanism. In comparison, NiO 700 exhibits a high crystallinity, but large crystallite sizes and a densified morphology, characteristics that reduce the active area and limit antimicrobial efficiency. Thus, the optimization of the calcination temperature should not only aim at maximizing structural order, but also at preserving the nanostructured character, essential for applications in the biomedical and water purification fields.
To contextualize the results obtained with NiO, it is relevant to compare it with copper oxide (CuO), another metal oxide with recognized antibacterial properties. Both materials act through similar mechanisms—the release of metal ions (Ni2+ and Cu2+, respectively), the generation of reactive oxygen species (ROS), and direct interaction with the cell membrane, but they present notable differences in their efficiency and toxicological profile. Studies reported in the literature show that CuO exhibits rapid and aggressive antibacterial activity, especially against Gram-positive bacteria, but with a higher toxic potential towards eukaryotic cells [18,19].
The demonstrated antimicrobial efficiency confirms the potential of these particles in biomedical and decontamination applications, especially in the context of infections resistant to conventional treatments. At the same time, the results emphasize the importance of choosing the synthesis conditions to maximize the antimicrobial performance of metal oxides.
Jassim et al. [13] showed that nanoparticles synthesized with clove extract (green synthesis) are more effective against Staphylococcus aureus than E. coli, attributing this to oxidative stress and released Ni2+ ions. In the present study, the complete inhibition of E. coli was observed at 72 h with the sample calcined at 300 °C, which is an exceptional result compared to the references. In the case of E. faecalis, the efficiency was lower at the beginning, but visible at 72 h, a behavior like that observed by Kesmez et al. [8], who mentioned a delayed bactericidal action.
5. Conclusions
NiO powders were obtained by hydrolytic synthesis at room temperature, using a 1 M solution of nickel nitrate (Ni(NO3)2·6H2O) and a 1 M solution of KOH, followed by calcination for 2 h at temperatures ranging from 300 °C to 900 °C, in order to evaluate the influence of heat treatment on the structural, morphological, and antibacterial properties of the powders. The cold precipitation method employed in this study promoted the initial nucleation of crystalline phases, facilitating the formation of nanoparticles with dimensions in the nanometric range. The structural identity of the synthesized NiO powders was confirmed by attenuated total reflectance Fourier transform infrared (ATR-FTIR) spectroscopy. All samples exhibited a characteristic absorption band associated with the stretching vibration of the Ni–O bond, thereby validating the successful formation of the nickel oxide phase across the different calcination temperatures.
X-ray diffraction (XRD) analyses proved the formation of a single crystalline phase of NiO (space group R-3m) for all tested temperatures. The average crystallite size increased significantly from 4.97 nm (300 °C) to approximately 17.8 nm (500–700 °C), followed by an unexpected decrease to 8.27 nm at 900 °C, suggesting the occurrence of structural defects or sintering effects. The unit cell volume remained relatively constant (~55 Å3), which confirmed the stability of the crystalline phase. Among all the samples, the one calcined at 300 °C presented the smallest crystallite size, which recommends it for applications where nanometric size is critical (e.g., catalysis, antimicrobial activity, and sensors). Thus, the sample calcined at 300 °C offers a valuable balance between the formation of the oxide phase and the preservation of the nanostructured character, justifying its choice as optimal in the context of the proposed synthesis.
Calcination temperature had a significant effect on the structural and chemical properties of the nickel oxide (NiO) particles. At 300 °C, the particles were small, irregular, and highly porous, features that promote surface activity and make them suitable for applications such as supercapacitors and catalytic systems. Increasing the temperature to 500 °C resulted in improved crystallinity, more defined grain boundaries, and moderate densification—beneficial for devices requiring both surface accessibility and conductivity. At 700 °C, grain coarsening and fusion led to a more compact structure with reduced porosity, while at 900 °C, the NiO particles exhibited large, polyhedral shapes with smooth facets, indicating advanced sintering and particle growth. Thus, optimizing the calcination temperature enabled the precise tuning of NiO morphology for specific functional applications, balancing between nanostructure preservation and material robustness.
The current work demonstrates that a simplified hydrolytic synthesis at room temperature can reproducibly yield hexagonal NiO nanocrystals. Furthermore, the crystallite sizes obtained here are comparable to or smaller than those reported in the literature, underscoring the effectiveness of the synthesis route in controlling nanoscale features critical to surface-sensitive applications.
Antibacterial tests showed a significant efficacy of NiO nanoparticles against Escherichia coli and Enterococcus faecalis, especially for the sample calcined at 300 °C, which demonstrated the complete inhibition of E. coli after 24 h, surpassing some results from the literature for green and hydrothermal syntheses. The efficacy was maintained at all temperatures, with notable differences depending on the bacterial strain and contact duration. In conclusion, calcination temperature has a major impact on the functional performance of NiO nanoparticles.
Therefore, this study demonstrates that hydrolytic synthesis at ambient temperature, followed by moderate calcination at 300 °C, is a simple, efficient, and scalable method for obtaining nanostructured NiO with high antibacterial activity, being comparable to more expensive or complex methods in the literature. The choice of 300 °C as the optimal temperature is justified not only by the minimum crystallite size, but also by the superior biological performance obtained. These results obtained support the use of hydrolytically synthesized NiO in areas such as water purification, antibacterial coatings, and biomedical devices.
Author Contributions
Conceptualization, A.-G.S.; methodology, A.-G.S.; software, M.O.; validation, A.-G.S., E.M.M. and M.O.; formal analysis, E.M.M., S.G.M. and D.A.N.; investigation, E.M.M., S.G.M., D.I. and D.A.N.; resources D.I.; data curation, E.M.M., S.G.M. and D.A.N.; writing—original A.-G.S. and D.I.; writing—review and editing, A.-G.S., E.M.M., M.O. and D.I.; visualization, M.O.; supervision, A.-G.S. All authors have read and agreed to the published version of the manuscript.
Funding
This research received no external funding.
Data Availability Statement
The original contributions presented in this study are included in the article. Further inquiries can be directed to the corresponding author.
Conflicts of Interest
The authors declare no conflicts of interest.
References
- Venter, A.; Botha, J.R. Optical and Electrical Properties of NiO for Possible Dielectric Applications. S. Afr. J. Sci. 2011, 107, 6. [Google Scholar] [CrossRef]
- Khandagale, P.; Shinde, D. Synthesis & Characterization of Nickel Oxide Nanoparticles by Using Co-Precipitation Method. Int. J. Adv. Res. 2017, 5, 1333–1338. [Google Scholar] [CrossRef]
- Hajra, K.; Maity, D.; Saha, S. Recent Advances of Metal Oxide Nanoparticles and Their Potential Applications: A Review. Adv. Mater. Lett. 2024, 15. [Google Scholar] [CrossRef]
- Gebreegziabher, H.G.; Yicheneku, Y.B.; Weldegebrieal, G.K. Synthesis of NiO Nanoparticles Using Chemical Precipitation Method for the Photocatalytic Degradation of Methylene Blue Dye. Lett. Appl. NanoBioSci. 2024, 13, 149. [Google Scholar] [CrossRef]
- Huang, Y.; Zhang, L.; Zhang, D.; Zhang, J.; Zhang, H.; Zeng, H. Sol-Gel Synthesis of NiO Nanoparticles Doped Sodium Borosilicate Glass with Third-Order Nonlinear Optical Properties. J. Alloys Compd. 2016, 686, 564–570. [Google Scholar] [CrossRef]
- Pooyandeh, S.; Shahidi, S.; Khajehnezhad, A.; Ghoranneviss, Z. Synthesizing and Deposition of Nickel Oxide Nanoparticles on Glass Mat Using Sol–Gel Method (Morphological and Magnetic Properties). J. Text. Inst. 2021, 112, 887–895. [Google Scholar] [CrossRef]
- Hashem, M.; Abd El-Aal, N.A.; Abu El-Reash, G.M.; El-Sayed, E.S.M.; Al-Motlak, M.A.; Abdel-Mottaleb, M.S.A. Fabrication and Characterization of Semiconductor Nickel Oxide (NiO) Nanoparticles Manufactured Using a Facile Thermal Treatment. Results Phys. 2016, 6, 1024–1030. [Google Scholar] [CrossRef]
- Kesmez, Ö.; Kuruca, T.; Odabaş, E.; Cihanoğlu, N.; Akarsu, E.; Demir, F. Synthesis and Characterization of Nickel Oxide Nanoparticles via Polyol-Mediated Hydrothermal Process with Antibacterial Properties. ChemistrySelect 2025, 10, e202405811. [Google Scholar] [CrossRef]
- Dudorova, D.A.; Romanov, V.P.; Tarasov, B.P.; Kharlamov, A.I. Hydrothermal Synthesis of Nickel Oxide and Its Application in the Additive Manufacturing of Planar Nanostructures. Molecules 2023, 28, 2515. [Google Scholar] [CrossRef] [PubMed]
- Miao, R.; Zeng, W.; Gao, Q. SDS-Assisted Hydrothermal Synthesis of NiO Flake-Flower Architectures with Enhanced Gas-Sensing Properties. Appl. Surf. Sci. 2016, 384, 304–310. [Google Scholar] [CrossRef]
- Narender, S.S.; Varma, V.V.S.; Srikar, C.S.; Ruchitha, J.; Varma, P.A.; Praveen, B.V.S. Nickel Oxide Nanoparticles: A Brief Review of Their Synthesis, Characterization, and Applications. Chem. Eng. Technol. 2022, 45, 397–409. [Google Scholar] [CrossRef]
- Hussain, S.; Khan, A.; Ullah, S.; Ahmad, M.; Riaz, R.; Wahab, Z.; Ul-Hamid, A. Green Synthesis of Nickel Oxide Nanoparticles Using Acacia nilotica Leaf Extracts and Investigation of Their Electrochemical and Biological Properties. J. Taibah Univ. Sci. 2023, 17, 2170162. [Google Scholar] [CrossRef]
- Jassim, S.M.; Abd, M.A.; Hammed, I.A. Green Synthesis of Nickel Oxide Nanoparticles Using Syzygium Aromatic Extract: Characterization and Biological Applications. Al-Bahir J. Eng. Pure Sci. 2023, 2, 2. [Google Scholar] [CrossRef]
- Faizan, M.; Fatima, M.; Shams, F.; Ibrahim, M.; Hussain, S.; Sabir, K.; Salman, S.; Ahmed, I.; Muzamil Arshad, M.; Khan, I. Plant Extract Mediated Biogenic Synthesis and Characterization of Nickel Oxide Nanoparticles and Its Environmental and Antibacterial Applications. J. Chem. Environ. 2023, 2, 109–121. [Google Scholar] [CrossRef]
- Mariam, A.A.; Kashif, M.; Arokiyaraj, S.; Bououdina, M.; Sankaracharyulu, M.G.V.; Jayachandran, M.; Hashim, U. Bio-Synthesis of NiO and Ni Nanoparticles and Their Characterization. Dig. J. Nanomater. Biostruct. 2014, 9, 1007–1019. [Google Scholar]
- Bhat, S.A.; Zafar, F.; Mondal, A.H.; Kareem, A.; Mirza, A.U.; Khan, S.; Mohammad, A.; Haq, Q.M.R.; Nishat, N. Photocatalytic Degradation of Carcinogenic Congo Red Dye in Aqueous Solution, Antioxidant Activity and Bactericidal Effect of NiO Nanoparticles. J. Iran Chem. Soc. 2020, 17, 215–227. [Google Scholar] [CrossRef]
- Ahmed, H.O.; Yaaqoob, L.A. Evaluation of Antibacterial Activity of Nickel Oxide Nanoparticles Against Escherichia Coli. Iraqi J. Agric. Sci. 2025, 56, 502–511. [Google Scholar] [CrossRef]
- Pattadakal, S.; Ghatti, V.; Chapi, S.; G., V.; Kumarswamy, Y.K.; Raghu, M.S.; T., V.G.; Nandihalli, N.; Kasai, D.R. Poly(vinyl alcohol) Nanocomposites Reinforced with CuO Nanoparticles Extracted by Ocimum sanctum: Evaluation of Wound-Healing Applications. Polymers 2025, 17, 400. [Google Scholar] [CrossRef] [PubMed]
- Modan, E.M.; Schiopu, A.-G.; Moga, S.G.; Negrea, D.A.; Istrate, D.; Ciuca, I.; Oproescu, M. Advanced Copper Oxide Chemical and Green Synthesis: Characterization and Antibacterial Evaluation. Crystals 2025, 15, 7. [Google Scholar] [CrossRef]
Disclaimer/Publisher’s Note: The statements, opinions and data contained in all publications are solely those of the individual author(s) and contributor(s) and not of MDPI and/or the editor(s). MDPI and/or the editor(s) disclaim responsibility for any injury to people or property resulting from any ideas, methods, instructions or products referred to in the content. |
© 2025 by the authors. Licensee MDPI, Basel, Switzerland. This article is an open access article distributed under the terms and conditions of the Creative Commons Attribution (CC BY) license (https://creativecommons.org/licenses/by/4.0/).